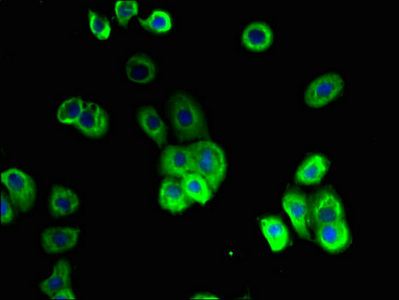

-
中文名稱:SLC10A2兔多克隆抗體
-
貨號:CSB-PA622519LA01HU
-
規格:¥440
-
圖片:
-
其他:
產品詳情
-
產品名稱:Rabbit anti-Homo sapiens (Human) SLC10A2 Polyclonal antibody
-
Uniprot No.:
-
基因名:
-
別名:Apical sodium dependent bile acid transporter antibody; Apical sodium- dependent bile acid transporter antibody; Apical sodium-dependent bile acid transporter antibody; ASBT antibody; IBAT antibody; ileal antibody; ileal apical sodium-dependent bile acid transporter antibody; Ileal Na(+)/bile acid cotransporter antibody; Ileal sodium dependent bile acid transporter antibody; Ileal sodium-dependent bile acid transporter antibody; Ileal sodium/bile acid cotransporter antibody; ISBT antibody; Na(+)-dependent ileal bile acid transporter antibody; Na+ bile acid cotransporter antibody; Na+ dependent ileal bile acid transporter antibody; NTCP2 antibody; NTCP2_HUMAN antibody; PBAM antibody; SLC10A2 antibody; Sodium/taurocholate cotransporting polypeptide antibody; Sodium/taurocholate cotransporting polypeptide; ileal antibody; solute carrier family 10 (sodium/bile acid cotransporter family) antibody; Solute carrier family 10 (sodium/bile acid cotransporter family); member 2 antibody; Solute carrier family 10 member 2 antibody
-
宿主:Rabbit
-
反應種屬:Human
-
免疫原:Recombinant Human Ileal sodium/bile acid cotransporter protein (306-348AA)
-
免疫原種屬:Homo sapiens (Human)
-
標記方式:Non-conjugated
本頁面中的產品,SLC10A2 Antibody (CSB-PA622519LA01HU),的標記方式是Non-conjugated。對于SLC10A2 Antibody,我們還提供其他標記。見下表:
-
克隆類型:Polyclonal
-
抗體亞型:IgG
-
純化方式:>95%, Protein G purified
-
濃度:It differs from different batches. Please contact us to confirm it.
-
保存緩沖液:Preservative: 0.03% Proclin 300
Constituents: 50% Glycerol, 0.01M PBS, PH 7.4 -
產品提供形式:Liquid
-
應用范圍:ELISA, IHC, IF
-
推薦稀釋比:
Application Recommended Dilution IHC 1:20-1:200 IF 1:50-1:200 -
Protocols:
-
儲存條件:Upon receipt, store at -20°C or -80°C. Avoid repeated freeze.
-
貨期:Basically, we can dispatch the products out in 1-3 working days after receiving your orders. Delivery time maybe differs from different purchasing way or location, please kindly consult your local distributors for specific delivery time.
-
用途:For Research Use Only. Not for use in diagnostic or therapeutic procedures.
引用文獻
- Enhanced Oral Absorption and Liver Distribution of Polymeric Nanoparticles through Traveling the Enterohepatic Circulation Pathways of Bile Acid L Wang,ACS applied materials & interfaces,2023
相關產品
靶點詳情
-
功能:Plays a critical role in the sodium-dependent reabsorption of bile acids from the lumen of the small intestine. Plays a key role in cholesterol metabolism.
-
基因功能參考文獻:
- A cysteine-less form of hASBT was made by creating point mutations at all 13 endogenous cysteines. Cysless hASBT had significantly reduced function correlated with lowered surface expression.Chemical cross-linking of wild-type and Cysless species revealed that hASBT has a dominant negative effect and exists as an active dimer and/or higher order oligomer with apparently no requirement for endogenous cysteine residues. PMID: 29198943
- Two single-nucleotide polymorphisms at novel loci, rs112404845 (P = 3.8 x 10-8), upstream of COBL, and rs16961023 (P = 4.6 x 10-8), downstream of SLC10A2, obtained genome-wide significant evidence of association with the posterior liability of late-onset Alzheimer's disease in African Americans. PMID: 27770636
- Data (including data from studies in knockout/transgenic mice) suggest that SLC10A2 is a functional receptor for hepatitis D virus in hepatocytes. PMID: 25902143
- Results unravel novel roles for N-glycosylation of ASBT and suggest that high levels of glucose alter the composition of the glycan and may contribute to the increase in ASBT function in diabetes mellitus. PMID: 25855079
- The p.Ser267Phe NTCP variant is significantly associated with resistance to chronic hepatitis B and a lower incidence of acute-on-chronic liver failure. Our results support that NTCP is a cellular receptor for HBV in human infection PMID: 25418280
- Data indicate that the lipid flippase (ATP8B1)-transmembrane protein 30A (CDC50A) heterodimer is essential for the apical localization of sodium-dependent bile acid transporter (SLC10A2/ASBT) in Caco-2 cells. PMID: 25239307
- It was conclude that regulation of ASBT expression by resveratrol (RSV) may have clinical relevance with regard to the observed cholesterol-lowering effects of RSV. PMID: 24498857
- Transmembrane domain II of the human bile acid transporter SLC10A2 coordinates sodium translocation. PMID: 24045943
- ASBT evolved from the earliest vertebrates by gaining affinity for modern bile salts while retaining affinity for older bile salts PMID: 22669917
- This study provided novel evidence for the alterations in the activity of ASBT by enteropathogenic Escherichia coli infection. PMID: 22403793
- There was no significant association of rs9514089 with gallstone risk, serum lipid parameters and BMI in the Sorbs and in the meta-analysis of all three cohorts. [meta-analysis] PMID: 22093174
- Presence of multiple functionally relevant variants in SLC10A2 that may influence bile acid homeostasis and physiology. PMID: 21649730
- The human ASBT promoter was activated transcriptionally by CDX1 and CDX2. PMID: 22016432
- The beneficial effect of rifampicin in cholestasis is associated with an increase in DME expression involved in toxic, bile acid and cholesterol metabolism, as well as a reduction in the bile acid importing system in hepatocytes. PMID: 21526375
- data demonstrate that TM1 plays a pivotal role in ASBT function and stability, thereby providing further insight in its dynamic transport mechanism PMID: 21646357
- the essential role of ASBT in the uptake of bile acids, by which the enterohepatic recirculation of bile acids is maintained PMID: 21341987
- Results show that bile acid conjugates are potential prolonged release prodrugs with binding affinity for ASBT. PMID: 20600720
- These data confirm that bile acids and upregulation of ASBT play a crucial role in NEC pathogenesis and suggest that inhibition of ASBT could be utilized as a therapeutic modality against this disease. PMID: 20616306
- Data demonstrate a novel role of lipid rafts in the modulation of ASBT function by the dietary component EGCG, which may underlie the hypocholesterolemic effects of green tea. PMID: 20056894
- SLC10A2 is a novel susceptibility gene for cholelithiasis in humans PMID: 19823678
- There was no apparent correlation between the SLC10A2 polymorphisms and bile acid production or turnover in familial hypertriglyceridemia patients. PMID: 11742882
- reglation of the ASBT gene by PPARalpha PMID: 12055195
- role in transport of bile acids in multidrug-resistance-protein 3-overexpressing cells PMID: 12220224
- Positively regulated by retinoic acid. Bile acids induce negative feedback regulation of human ASBT via farnesoid X-receptor-mediated, short heterodimer partner-dependent effect upon retinoic acid receptor/retinoid X receptor activation of ASBT. PMID: 15239098
- SLC10A2 expression is regulated by the ubiquitin-proteasome pathway PMID: 15304498
- On the basis of seven transmembrane topology, a three-dimensional model of ASBT is built. The model agrees with available data for pathological mutation P290S because the mutant model after in silico mutagenesis loses the ability to bind bile acids. PMID: 15350125
- BIle acid-methanethiosulfonyl can serve as novel and powerful tools to probe the role of endogenous as well as engineered Cys residues in the bile acid binding region(s) of hASBT. PMID: 15952798
- current data provide the first evidence that I-BABP is functionally associated with FXR and IBAT in the nucleus and on the membrane, respectively, stimulating FXR transcriptional activity and the conjugated bile acid uptake mediated by IBAT in the ileum PMID: 16230354
- ASBT and ILBP protein were 48% and 67% lower in normal weight gallstone carriers than in controls (P < 0.05); similar differences were found for mRNA expression levels. PMID: 16237211
- this study determines a 7TM topology for hASBT and refutes the previously proposed 9TM model PMID: 16411770
- hASBT-mediated prodrug targeting is discussed, including QSAR, in vitro models for hASBT assay, and the current progress in utilizing hASBT as a drug delivery target. PMID: 16749855
- Although the presence of a single negative charge was not essential for interaction with hASBT, monoanionic conjugates are favored for hASBT-mediated transport compared to cationic and zwitterionic conjugates. PMID: 16749860
- These data suggest that transmembrane segment 7 (TM7) plays a dominant role in the hASBT translocation process. PMID: 16899538
- One or more constituents of human serum stimulate ASBT gene expression largely via the down-stream AP-1 response element. PMID: 17942302
- Extracellular loop 3 amino acids are essential for human ASBT activity as primary substrate interaction points using long-range electrostatic attractive forces. PMID: 18028035
- cholesterol content of lipid rafts is essential for the optimal activity of ASBT PMID: 18063707
- involvement of transmembrane domain 4 (TM4) of hASBT in forming the putative translocation pathway. TM4 has distinct helical face that contains residues critical for transport & conformational stability. PMID: 18311924
- analysis of how conserved aspartic acid residues lining the extracellular loop 1 of sodium-coupled bile acid transporter ASBT interact with Na+ and 7alpha-OH moieties on the ligand cholestane skeleton PMID: 18508772
- Common variants of the SLC10A2 gene are not associated with sporadic or familial colorectal cancer PMID: 18644122
- dysfunction, and impaired adaptive responses of several of the bile acid transporters, e.g. BSEP and ASBT, results in liver and intestinal disease PMID: 18668439
- Cyclic AMP-mediated phosphoinositide-3-kinase{ISBT)-independent activation of Rab4 facilitates Ntcp translocation in a hepatoma cell line. PMID: 18688880
- haplotype carriers with the minor allele exhibited significant reduced ileal SLC10A2 expression on mRNA levels (2.6-fold, P = 0.0009) and protein levels (2.4-fold, P = 0.0157) PMID: 19184108
- Integration of results for transmembrane (TM)3 and TM7 cysteine mutants suggests a putative scenario to describe substrate entry and exit into the ASBT permeation pathway during translocation mechanisms. PMID: 19653651
顯示更多
收起更多
-
相關疾病:Primary bile acid malabsorption (PBAM)
-
亞細胞定位:Membrane; Multi-pass membrane protein.
-
蛋白家族:Bile acid:sodium symporter (BASS) (TC 2.A.28) family
-
數據庫鏈接:
Most popular with customers
-
-
YWHAB Recombinant Monoclonal Antibody
Applications: ELISA, WB, IHC, IF, FC
Species Reactivity: Human, Mouse, Rat
-
Phospho-YAP1 (S127) Recombinant Monoclonal Antibody
Applications: ELISA, WB, IHC
Species Reactivity: Human
-
-
-
-
-